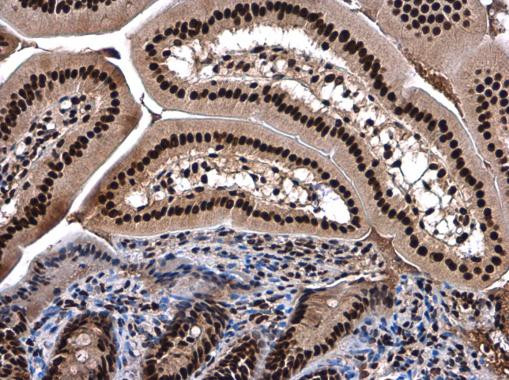
SMARCC2 Antibody in Immunohistochemistry (Paraffin) (IHC (P))

Search
Invitrogen
SMARCC2 Polyclonal Antibody
{{$productOrderCtrl.translations['antibody.pdp.commerceCard.promotion.promotions']}}
{{$productOrderCtrl.translations['antibody.pdp.commerceCard.promotion.viewpromo']}}
{{$productOrderCtrl.translations['antibody.pdp.commerceCard.promotion.promocode']}}: {{promo.promoCode}} {{promo.promoTitle}} {{promo.promoDescription}}. {{$productOrderCtrl.translations['antibody.pdp.commerceCard.promotion.learnmore']}}
产品信息
PA5-85414
种属反应
宿主/亚型
分类
类型
抗原
偶联物
形式
浓度
规格
纯化类型
保存液
内含物
保存条件
运输条件
RRID
产品详细信息
Keep as concentrated solution.
Predicted reactivity: Mouse (95%), Xenopus laevis (83%), Bovine (99%).
Positive Control: MCF-7, MDA-MB-231.
Store product as a concentrated solution. Centrifuge briefly prior to opening the vial.
靶标信息
Cdc73 is a tumor suppressor probably involved in transcriptional and post-transcriptional control pathways. Cdc73 is part of the PAF1 complex, a five-subunit protein complex composed of Paf1, Cdc73, Leo1, Rtf1 and Ctr9. PAF1 was first purified from yeast in association with RNA polymerase II and is believed to function in transcription elongation. The yeast PAF (yPAF) complex interacts with RNA polymerase II and coordinates the setting of histone marks associated with active transcription. In addition to coordinating events during transcription (initiation, promoter clearance, and elongation), hPAF also coordinates events in RNA quality control. Cdc73 may also be involved in cell cycle progression through the regulation of cyclin D1/PRAD1 expression.
仅用于科研。不用于诊断过程。未经明确授权不得转售。
篇参考文献 (0)
生物信息学
蛋白别名: BAF170; BRG1-associated factor 170; chromatin remodeling complex BAF170 subunit; DKFZp313D0632; mammalian chromatin remodeling complex BRG1-associated factor 170; similar to SWI/SNF-related matrix-associated actin-dependent regulator of chromatin c2; SWI/SNF complex 170 kDa subunit; SWI/SNF complex subunit SMARCC2; SWI/SNF related, matrix associated, actin dependent regulator of chromatin subfamily c member 2; SWI/SNF-related matrix-associated actin-dependent regulator of chromatin subfamily C member 2; SWI3-like protein; unnamed protein product
基因别名: 5930405J04Rik; BAF170; CRACC2; CSS8; Rsc8; SMARCC2
UniProt ID: (Human) Q8TAQ2, (Mouse) Q6PDG5
Entrez Gene ID: (Rat) 685179, (Human) 6601, (Mouse) 68094